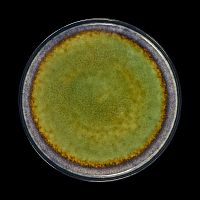
ТАРЕЛКА мелкая 10,5" 265мм, синий+зеленый "Corone Verde"

Каталог товаров
-
Посуда кухонная производственная
-
Нейтральное оборудование
-
Термосы армейские и бытовые, ланч-боксы
-
Тепловое оборудование
-
Холодильное оборудование
- Оборудование для сельскохозяйственной отросли
-
Технологическое оборудование
-
Хлебопекарное и кондитерское оборудование
-
Барное оборудование
-
Вендинговые автоматы
-
Весовое и упаковочное оборудование
-
Посудомоечные машины
-
Прачечное оборудование
Уточнить раздел
- Посуда из фарфора 6
- Горшочки для тушения 2
- Посуда Bonna серия Coral 16
- Посуда Bonna серия Kids 6
- Посуда Bonna серия Viento 34
- Посуда By Bone серия Cowry Yellow 24
- Посуда By Bone серия Edera 26
- Посуда By Bone серия Elegance 58
- Посуда By Bone серия Infinity 65
- Посуда By Bone серия Supreme 56
- Посуда By Bone серия Tinta Spazio 17
- Посуда By Bone серия Tropikal 27
- Посуда By Bone серия Vintage 59
- Посуда Chan Wave серия Classic 75
- Посуда Chan Wave серия Quadro 27
- Посуда Corone Alveare 22
- Посуда Corone Rosenthal 63
- Посуда Corone Rosenthal Hotel 14
- Посуда Corone Sacramento 26
- Посуда Corone White 100
- Посуда Corone серия Aqua 19
- Посуда Corone серия Celeste 54
- Посуда Corone серия Gourmet 38
- Посуда Corone серия Gourmet Colore 27
- Посуда Corone серия Gusto 30
- Посуда Corone серия Luminare 24
- Посуда Corone серия Natura 55
- Посуда Corone серия Oceano 14
- Посуда Corone серия Primavera 18
- Посуда Corone серия Rust 17
- Посуда Corone серия Terra 22
- Посуда Corone серия Urbano 29
- Посуда Corone серия Verde 31
- Посуда Corone серия Сarmen 27
- Посуда Cuong Phat 10
- Посуда Cuong Phat серия Acquamarina 13
- Посуда LY'S серия Horeca 50
- Посуда Sam&Squito серия Classic 62
- Посуда Sam&Squito серия Quadro 32
- Посуда для детских садов 11
- Посуда для японской кухни 3
- Посуда серия Black Star 82
- Посуда серия Noble 27
- Сервизы 8
- Серия Collage 60
- Серия Lambert 38
- Серия Tvist Ivory 25
- Серия Tvist Madeira 17
- Серия Восток 8
- Стеклокерамика Arcopal Trianon 22
- Фарфор Albero 19
- Фарфор Bushido 24
- Фарфор Corone Calypso 20
- Фарфор Corone Grafica 27
- Фарфор Corone Rosenthal Banquet 11
- Фарфор Corone Villaggio 22
Фильтр по параметрам
Подписка на новости магазина
Подпишитесь на рассылку и получайте свежие новости и акции нашего магазина.
Посуда Corone серия Verde
Сортировать по:
популярности
популярности
алфавиту
увеличению цены
уменьшению цены
Показать по:
60
60
120
180



 В корзину
В корзину Купить в 1 клик
Купить в 1 клик Сравнение
Сравнение В избранное
В избранное Под заказ
Под заказ

![Лопатка перфорированная 240 мм Luxstahl нержавеющая сталь [C24-07] купить Лопатка перфорированная 240 мм Luxstahl нержавеющая сталь [C24-07]](/upload/resize_cache/iblock/d84/220_200_1/d2xxvas6ozegabvixavjuoq5dx7b7uz3.jpg)













